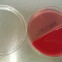

Need reference material on Medical Technology subject matter? Yes! Detailed lecture notes are available for the following major subject area needed to successfully pass the major MLT/MT/MLS Certification Examinations in… Continue Reading →
.................. MLS  Tutor..................Medical Laboratory Science ~ Clinical Laboratory Science ~ Medical Technology
Tutor..................Medical Laboratory Science ~ Clinical Laboratory Science ~ Medical Technology
 Tutor..................Medical Laboratory Science ~ Clinical Laboratory Science ~ Medical Technology
Tutor..................Medical Laboratory Science ~ Clinical Laboratory Science ~ Medical TechnologyServices

Reference Access
$30 - $50 / course
Premium Access
MLT/MT/MLS Gain full access to the general forum, one-on-one interactive sessions (two 1-hour sessions per week or one 2-hour session per week), and ALL reference material for all subjects for… Continue Reading →
$800 / year
Certification Exam Review Access
Gives you one-on-one interactive sessions (two 1-hour sessions per week or one 2-hour session per week), access to exams, and other review materials for one time fee of $375 for… Continue Reading →
$375 / 3 months